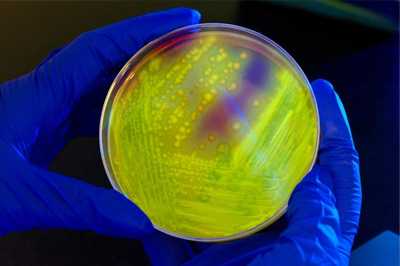

AMD Projects: Combating Healthcare-associated Infections
Building advanced molecular detection infrastructure to combat healthcare-associated infections
Clostridium difficile is a common cause of antibiotic-associated diarrhea.
Untreatable infections threaten a return to the time when simple infections were deadly. Hospitals and other healthcare settings battle to protect their patients from these drug-resistant organisms and prevent their spread to other patients. Predicting how these bacteria will become resistant is a challenge.
When investigating unfamiliar territory, such as the evolution of germs, the use of proven standardized investigative methods decreases confusion as multiple groups work to understand more about a pathogen. It is critical for partners to measure and investigate specific resistant bacteria in the same way, using a common vocabulary and accepted criteria. The study will decode the building blocks of genetic material to reveal how specific genes change and develop over time. This will create detailed family trees for two high-threat germs, Clostridium difficile—a germ that causes life-threatening diarrhea—and carbapenem -resistant Enterobacteriaceae (CRE)—a family of germs that have become resistant to all or nearly all the antibiotics we have today.
This study will help CDC establish a new, more robust standard to determine reliably the genetic history of drug-resistant bacteria. Understanding the genetic likeness will help in the development of protocols and procedures for testing and analysis. Ultimately, understanding how C. difficile and CRE have changed over time and how they spread will protect more people and reduce infections in healthcare settings.
Project Update
In the first two years of this project, CDC has been building advanced molecular detection (AMD) infrastructure to understand healthcare-associated infections (HAIs) and emerging antimicrobial resistance (AR) in these pathogens. Scientists have focused their work on determining how these germs are transmitted in healthcare settings, understanding various strains involved in outbreaks, and looking for new ways in which the pathogens become resistant to antimicrobials. The diversity of pathogens involved in HAIs has presented a challenge in this work because methods used to detect and study one germ typically do not work on the others, so scientists must devise new methods for each pathogen, and sometimes for various strains of the same pathogen. This is demonstrated by the 250 genomes sequenced from HAI outbreak and transmission studies, including studies of C. difficile, Clostridium septicum, E. coli, Klebsiella pneumoniae, Mycobacterium abscessus, Pseudomonas aeruginosa, Staphylococcus aureus, and Enterococcus faecalis.
Nonetheless, CDC investigators have made progress and participated in active surveillance of these pathogens. By adding AMD to surveillance, we can look more deeply at the characteristics of various strains, determine if existing medications will be effective against a circulating strain, track how infectious a strain is, and determine if the strain is developing new AR characteristics. CDC also shares information about these pathogens with the scientific community to ensure that researchers and drug manufacturers are working with the most current strains of HAIs that we find in healthcare settings. Ongoing work in this area will help us detect and treat HAIs faster and more effectively.
PRINCIPAL INVESTIGATOR PROFILE

Brandi M. Limbago, PhD
Deputy Chief, Clinical and Environmental Microbiology Branch
Division of Healthcare Quality Promotion
National Center for Emerging and Zoonotic Infectious Diseases
Brandi Limbago, Ph.D., Deputy Chief of the Clinical and Environmental Microbiology Branch in the
Division of Healthcare Quality Promotion (DHQP) at CDC’s National Center for Emerging and Zoonotic Infectious Diseases, leads a group of laboratory scientists that serves as a national reference laboratory for detection of antimicrobial resistance and investigates healthcare-associated infections . This group studies methods for the reliable detection of antimicrobial resistance, emergence of novel resistance mechanisms, and the molecular epidemiology of common healthcare-associated infections, including carbapenem -resistant Enterobacteriaceae (CRE), Clostridium difficile, and methicillin-resistant Staphylococcus aureus (MRSA)..
Dr. Limbago received her undergraduate degree from the College of Idaho and her PhD from Emory University. She completed clinical microbiology training at University of Washington Medical Center. She is a member of the Clinical Laboratory Standards Institute Subcommittee on Antimicrobial Susceptibility Testing and co-chair of its Methodology Working Group. In addition, Dr. Limbago is an associate editor for Anaerobe.
- Page last reviewed: March 22, 2016
- Page last updated: March 22, 2016
- Content source:


 ShareCompartir
ShareCompartir